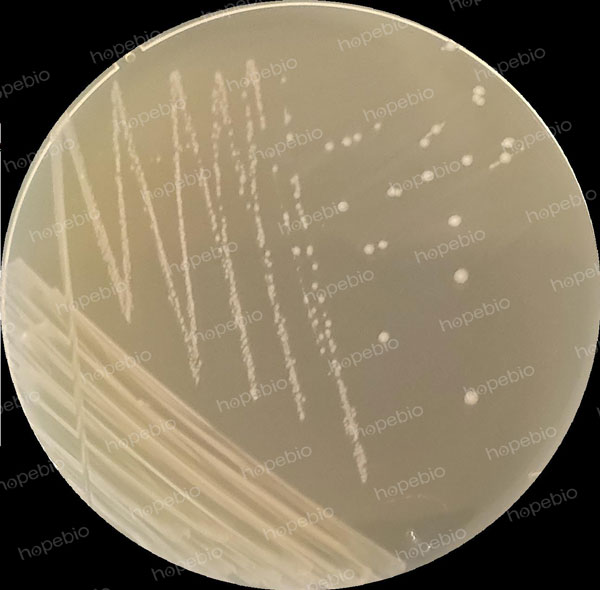

海博微信公众号
海博微信公众号
 海博天猫旗舰店
海博天猫旗舰店


 海博微信公众号
海博微信公众号
 海博天猫旗舰店
海博天猫旗舰店




一、产品用途及原理
用于鼠伤寒沙门氏菌回复突变试验(Ames试验)。
V-B10E提供氮源和生长因子,葡萄糖是可发酵的糖,琼脂是凝固剂,磷酸氢钠铵可为微生物的生长提供所需的营养物质。
二、培养基配方(g/L)
|
V-B10E |
12.2 |
|
葡萄糖 |
20.0 |
|
琼脂 |
15.0 |
|
pH值7.0±0.2(25℃) |
|
三、试验方法
1、称取本品47.2g,另取磷酸氢钠铵3.5g,加热溶解于1000mL蒸馏水中,分装三角瓶,115℃高压灭菌30分钟,倾注无菌平皿,备用。
2、接种质控菌株,划线接种至培养基中。
3、放置于35℃需氧培养24h-48h。
四、质控结果
接种以下质控菌株,放置于35℃需氧培养24h-48h,如图1所示。
|
质控菌株 |
菌株编号 |
接种量 |
质控结果 |
|
鼠伤寒沙门氏菌 |
ATCC 14028 |
/ |
生长良好 |
图1 最低营养V-B培养基(底层)的质控结果
相关产品:
注:本文属海博生物原创,未经允许不得转载。



